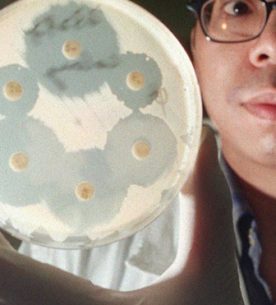

-
«دو دلار برای هر نفر در سال» می تواند ابر باکتریهای مرگبار را متوقف کند
۱۸ آبان ۱۳۹۷۰توریست مالزی – سازمان همکاری و توسعه اقتصادی (OECD) روز چهارشنبه گفت عفونتهای ناشی از «ابر باکتری ها» که هر سال جان میلیونها نفر را در سراسر جهان می گیرد می توان با هزینه کردن دو... -
بلافاصله پس از خوردن غذا این کارهای مرگبار را انجام ندهید
۱۲ آبان ۱۳۹۶توریست مالزی – شده تا به حال به این فکر کنید چرا بعضی افراد زیاد دچار بیماریهای معده و روده میشوند، یا مدام شکمشان نفخ دارد و ناگهانی در خواب سکته میکنند. به گزارش قطره، این...
۳ خرداد ۱۴۰۵ / 24 May 2026